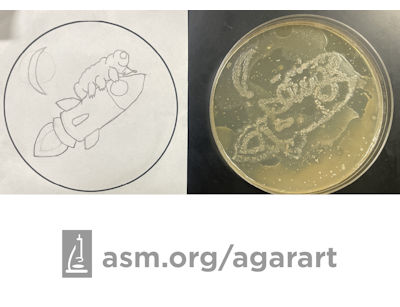
Agar Art of a tardigrade in space.

ASM Announces 2023 Agar Art Contest Winners
Washington, D.C.—The American Society for Microbiology (ASM) announces the winners of the 9th annual Agar Art Contest, which drew a record-breaking 390 submissions from artists in 37 countries. Since 2015, ASM’s Agar Art Contest has given scientists and artists a platform to showcase their creativity by using live microbes to “paint” images on agar, a gelatin-like substance that serves as food for the microorganisms. Artists may also submit entries to the “Open” category, using any artistic medium for their works. The artists this year were given the theme of "Microbiology in Space.”“The artists creatively highlight the relationship between science and art with the power of microbes,” said Geoff Hunt, the Public Outreach Program Officer at ASM. “The creators used this year’s theme to juxtapose microscopic organisms with the vastness of space.”
This year’s annual Agar Art Contest was sponsored by MilliporeSigma,* a leader in innovative life science products and services, supporting prizes awarded to the contest winners. MilliporeSigma will also support travel for the winner of the “Professional” category to the company’s world class agar plate production site in Molsheim, France to take part in a live Agar Art exhibit event in 2024. ASM’s Agar Art Contest was also supported by Edvotek, which provided an Agar Art kit to the winner of ASM’s social media contest.
Submissions to the “Professional” category came from individuals with regular access to laboratory space and materials. Ella Rotman at the University of Chicago, who has submitted art to the contest every year since its inception, won 1st place in this category with “Alien Medley.” Both capsulated and non-capsulated variants of Klebsiella pneumoniae were used to draw the aliens.

Source: American Society for Microbiology
Taking 2nd place in the “Professional” category with “Agarnaut” is Svenja Ries, a research technician at BRAIN Biotech AG in Germany.

Source: American Society for Microbiology
Winning 3rd place in this category with their piece “Microbial Perseverance” are Camilo Berríos-Pastén, Amelia Cox-Fermandois, A. Victoria Suárez-Clerc, Hazajem Colque-Ferrer and Andrés E. Marcoleta at Universidad de Chile.

Source: American Society for Microbiology
In the “Creator” category, Shashank Yadav of the Amity University Mumbai, India, won 1st place with “A Cosmic Journey of Yeast Cells.” The art, created with 4 different microbes, depicts the journey of BioSentinel, a small satellite carrying yeast cells through the vastness of space.

Source: American Society for Microbiology
The 1st place spot for the “Open” category went to Sunskritha Shivaprasad, a student at the Vidya Niketan School, for “Irradiating Microbes.” Using cotton stretch canvas, acrylic paint, markers and gold leaf, it shows the extreme environmental factors faced by microbes in space—including solar UV radiation, varying temperatures and existing in a vacuum.

Source: American Society for Microbiology
The “Kids” category accepts art submissions from artists aged 12 years old and younger. The 1st place winner in this category is Ambria Adair of Knudson Academy of the Arts. The winning art piece, “The Rocket Bear,” shows a tardigrade surfing through space on a spaceship. The art was created using Sarcina aurantiaca.
Source: American Society for Microbiology
*MilliporeSigma is the U.S. and Canada Life Science business of Merck KGaA, Darmstadt, Germany.
###
The American Society for Microbiology is one of the largest professional societies dedicated to the life sciences and is composed of 36,000 scientists and health practitioners. ASM's mission is to promote and advance the microbial sciences.
ASM advances the microbial sciences through conferences, publications, certifications, educational opportunities and advocacy efforts. It enhances laboratory capacity around the globe through training and resources. It provides a network for scientists in academia, industry and clinical settings. Additionally, ASM promotes a deeper understanding of the microbial sciences to diverse audiences.
#
MilliporeSigma’s* portfolio spans more than 300,000 products with 19,000 employees and 72 manufacturing sites worldwide. Our BioMonitoring portfolio offers a complete range of high-quality microbial testing solutions for industrial applications while also providing regulatory expertise, comprehensive services and collaborative partnerships that you can trust. We support you at every stage of the workflow with trusted, intuitive products and services for lab efficiency and regulatory compliance, backed by technical expertise and quality systems.
